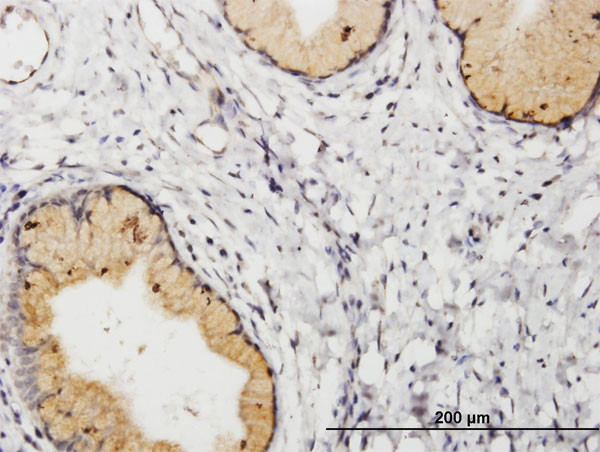
PGF Antibody in Immunohistochemistry (Paraffin) (IHC (P))

Search
Abnova
PGF Polyclonal Antibody, MaxPab™
{{$productOrderCtrl.translations['antibody.pdp.commerceCard.promotion.promotions']}}
{{$productOrderCtrl.translations['antibody.pdp.commerceCard.promotion.viewpromo']}}
{{$productOrderCtrl.translations['antibody.pdp.commerceCard.promotion.promocode']}}: {{promo.promoCode}} {{promo.promoTitle}} {{promo.promoDescription}}. {{$productOrderCtrl.translations['antibody.pdp.commerceCard.promotion.learnmore']}}
产品信息
H00005228-B01P
宿主/亚型
分类
类型
抗原
偶联物
形式
浓度
规格
保存条件
运输条件
产品详细信息
Sequence of this protein is as follows: MPVMRLFPCF LQLLAGLALP AVPPQQWALS AGNGSSEVEV VPFQEVWGRS YCRALERLVD VVSEYPSEVE HMFSPSCVSL LRCTGCCGDE NLHCVPVETA NVTMQLLKIR SGDRPSYVEL TFSQHVRCEC RPLREKMKPE RRRPKGRGKR RREKQRPTDC HLCGDAVPRR
靶标信息
Placental growth factor (PlGF) is a member of the vascular endothelial growth factor (VEGF) family. PlGF is a pleiotropic factor affects different cell types and regulates various biological responses. The activity of vascular endothelial growth factor (VEGF), which is the most potent of all angiogenic mediators, is partly modulated by PlGF. It plays a major role in vasculogenesis and angiogenesis in human placenta.
仅用于科研。不用于诊断过程。未经明确授权不得转售。